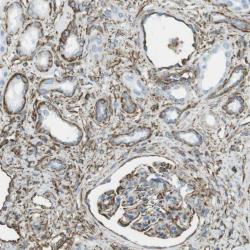

Antibody data
- Antibody Data
- Antigen structure
- References [1]
- Comments [0]
- Validations
- Immunohistochemistry [1]
Submit
Validation data
Reference
Comment
Report error
- Product number
- sc-33710 - Provider product page

- Provider
- Santa Cruz Biotechnology
- Proper citation
- Santa Cruz Biotechnology Cat#sc-33710, RRID:AB_2229746
- Product name
- Anti-COL7A1
- Antibody type
- Monoclonal
- Reactivity
- Human
- Host
- Mouse
Submitted references Electro-optical Synergy Technique: A New and Effective Nonablative Approach to Skin Aging.
El-Domyati M, El-Ammawi TS, Medhat W, Moawad O, Mahoney MG, Uitto J
The Journal of clinical and aesthetic dermatology 2010 Dec;3(12):22-30
The Journal of clinical and aesthetic dermatology 2010 Dec;3(12):22-30
No comments: Submit comment
Supportive validation
- Submitted by
- per
- Main image
- Experimental details
- Immunohistochemical staining of human kidney shows distinct membranous positivity in cells in tubules and glomeruli.
- Validation comment
- Staining pattern partly consistent with experimental and/or bioinformatic data.